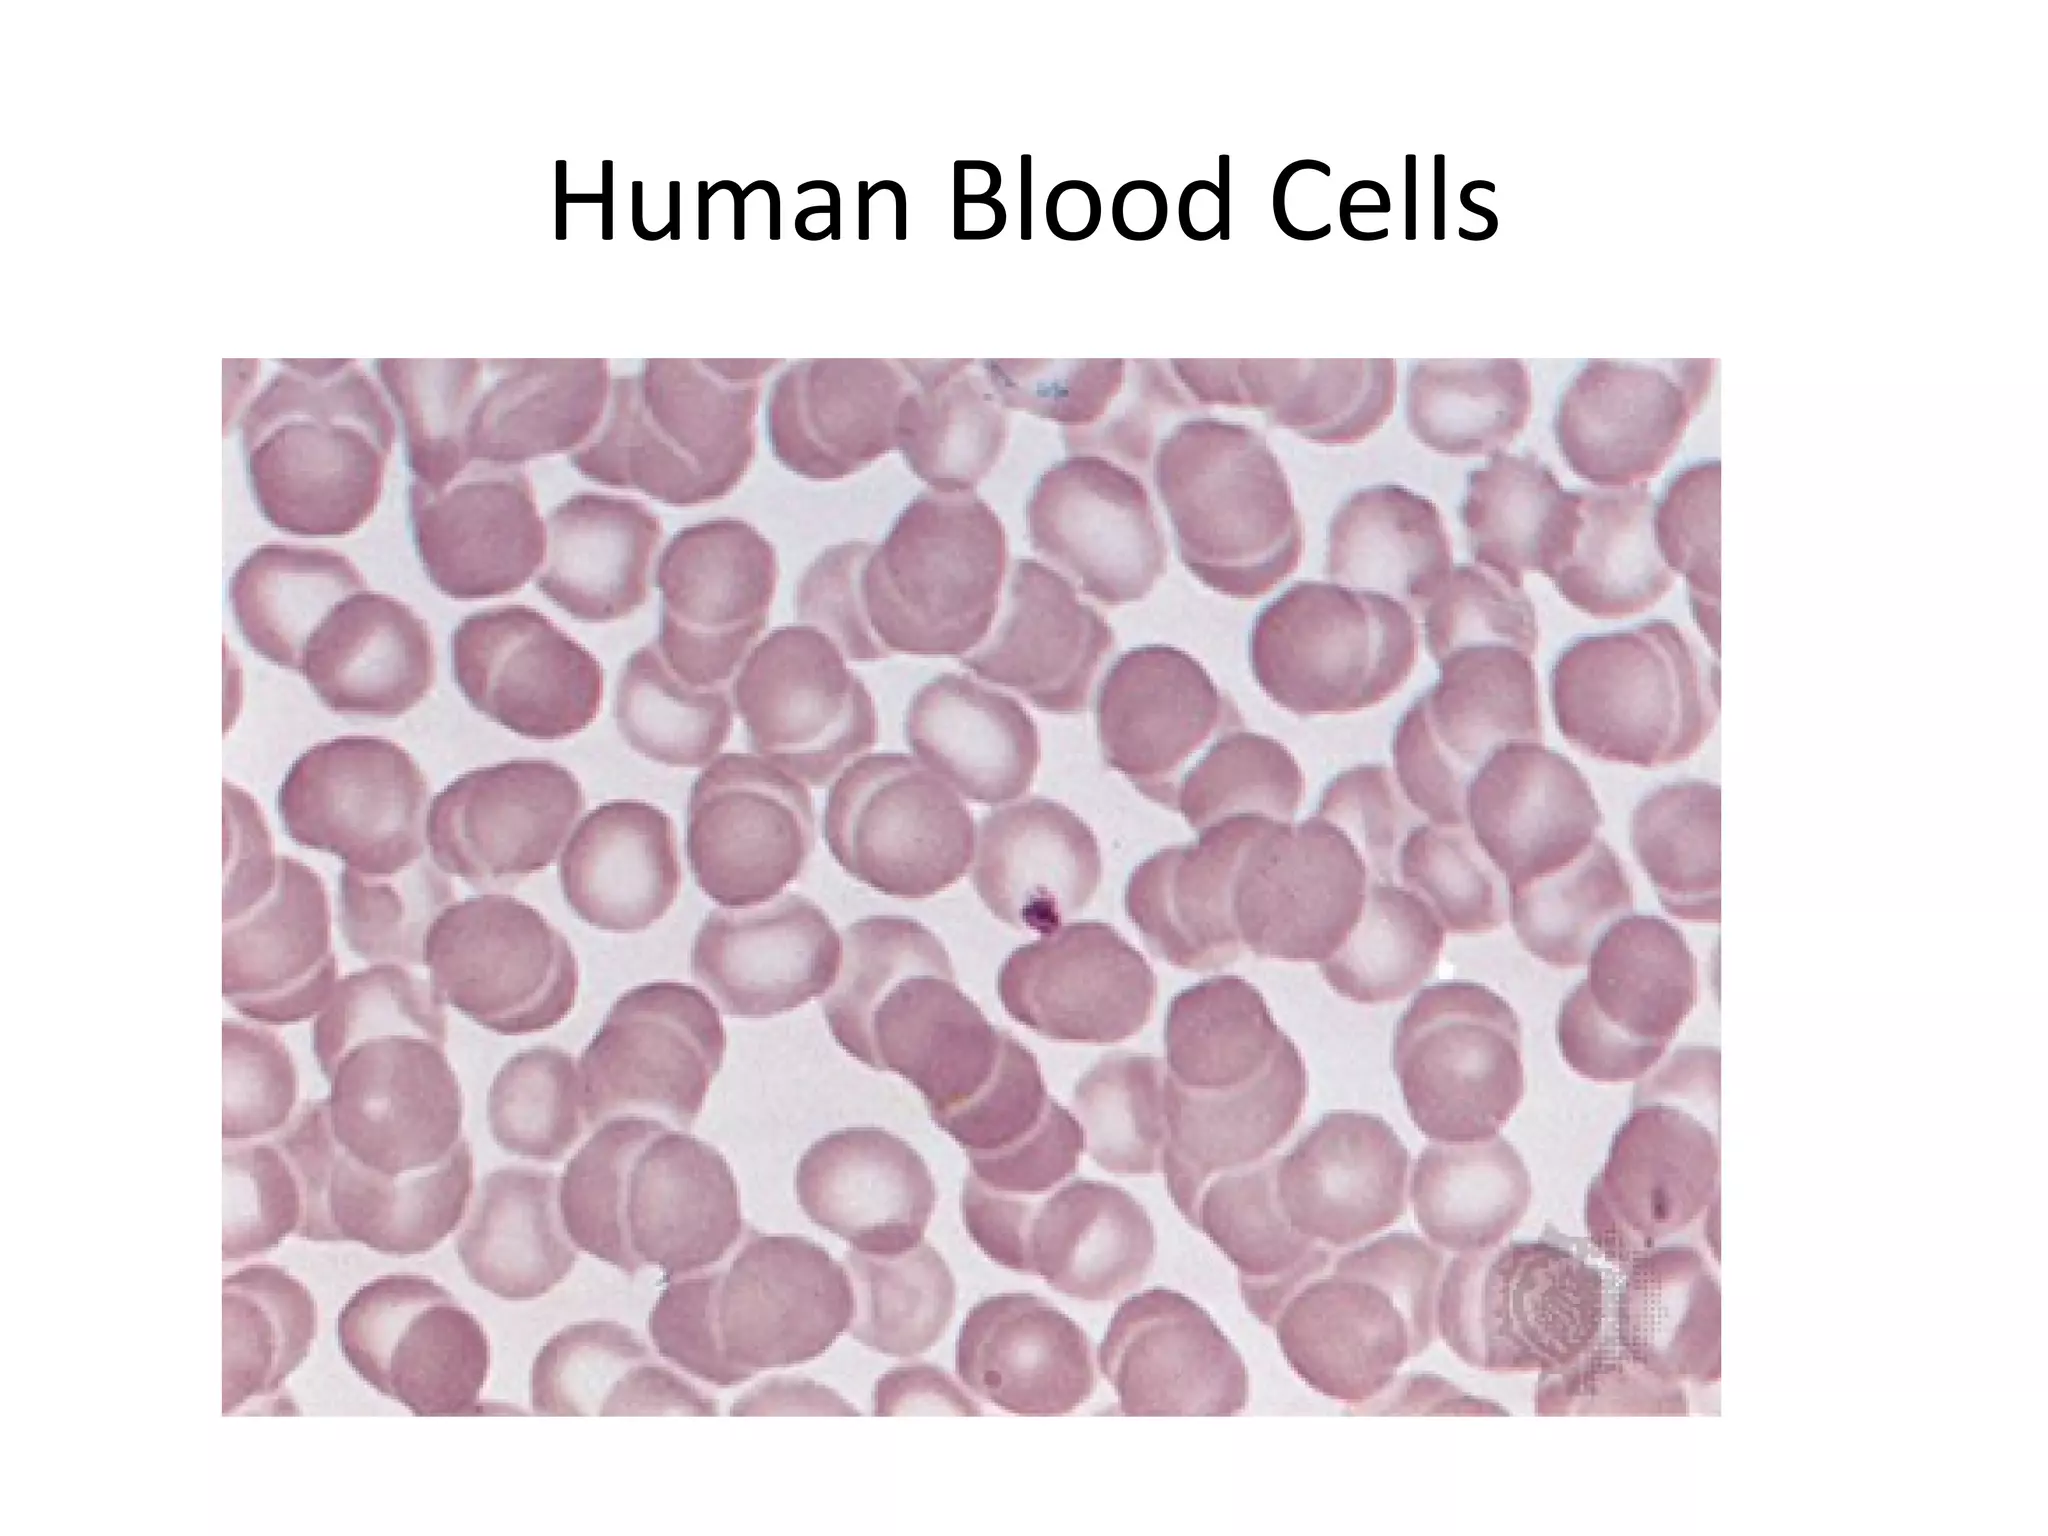
Human Blood Cells

Embed presentation
Downloaded 47 times








This document describes various plant and animal cell samples that were observed under a microscope including elodea, stained cheek cells, a potato with leucoplasts, stained onion cells, human blood cells, a flower petal, and cork cells.